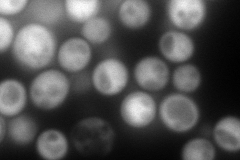
YBL001C
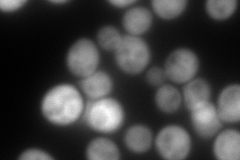
YBL001C
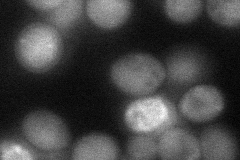
YBL001C
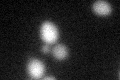
YBL001C
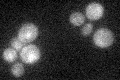
YBL001C

View description
Non-essential protein of unknown function, likely exists as tetramer, may be regulated by the binding of small-molecule ligands (possibly sulfate ions), may have a role in yeast cell-wall biogenesis
Localization:
Intensity:
Fold change:
Significance:
-
C’ GFP library in SD

cytosol26.26 -
N' NOP1pr-GFP in SD
cytosol309.95 -
N' TEF2pr-mCherry in SD
cytosol482.735 -
N' NATIVEpr-GFP in SD

cytosol64.0799 -
N' TEF2pr-VC and Cyto-VN in SD
cytosol53.3946 -
C’ GFP library in SD+DTT
cytosol24.630.93No -
C’ GFP library in SD+H2O2

cytosol27.31.03No -
C’ GFP library in Starvation Media
cytosol35.751.36No -
C’ GFP library on the background of Pup2-DaMP

cytosol -
C’ GFP library on the background of CCT mutant

cytosol18.0810.688338Yes
